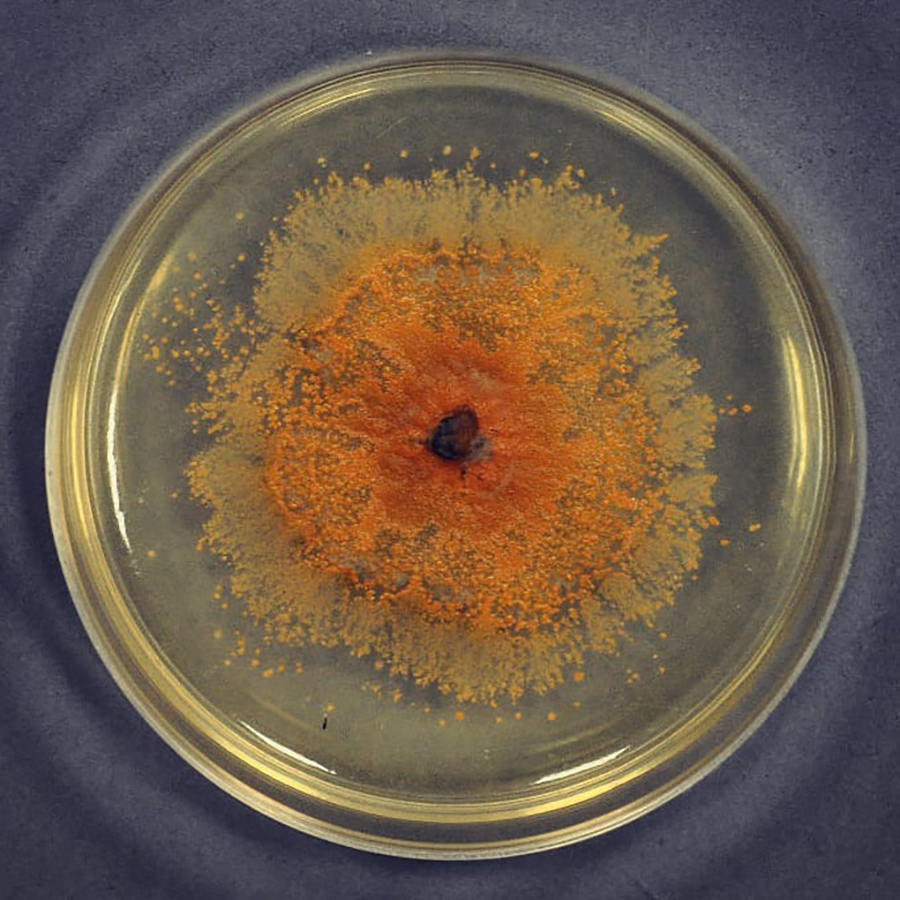

Le Dr Katarzyna Patejuk, du Département de Phytopathologie et de Mycologie de l’Université des Sciences de la Vie de Wrocław, a découvert une nouvelle espèce de champignon. La scientifique est tombée sur l’indice de Colletotrichum acericola alors qu’elle effectuait des recherches pour son doctorat. Elle a trouvé le champignon dans les rues Krakowska et Bytomska à Wrocław, sur les graines d’un érable à feuilles de frêne.
Selon la chercheuse, le champignon ne correspondait à aucune espèce connue auparavant. – J’ai donc décidé de l’examiner de plus près et, grâce à la coopération avec l’Académie Polonaise des Sciences – l’Institut de Botanique Szafer et l’Institut de Conservation de la Nature, ainsi qu’avec la Polytechnique de Bydgoszcz, il a été possible de décrire cette espèce de champignon « de Wrocław » », explique le Dr Patejuk, cité sur le site web de l’université.
La chercheuse ajoute que le champignon est intéressant parce qu’il diverge génétiquement de ses parents les plus proches : le complexe Colletotrichum agaves (il s’agit d’un complexe très étroit et, à l’exception d’une découverte en Europe, sur une plante commerciale, il n’a pas été enregistré jusqu’à présent sur des plantes sauvages européennes).
Pour en savoir plus : https://upwr.edu.pl/aktualnosci/badaczka-upwr-odkryla-nowy-gatunek-grzyba-4114.html









